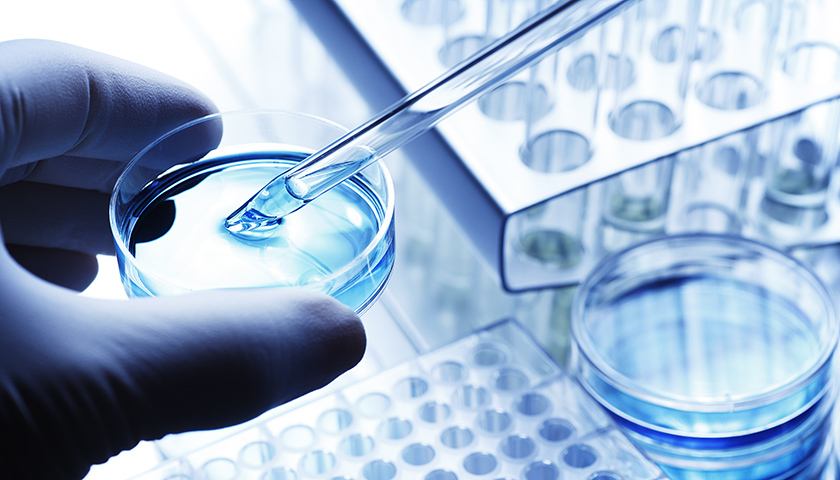
timg.jpg

疫情全球蔓延,生物医药或将迎难而上
2020年04月02日随着湖北医疗队的撤离,湖北逐步解封,第一批务工者也踏上了南下的列车,当前中国本土疫情传播基本阻断,中国抗疫阻击战取得重大成果。同时,我们也面临着不少新情况新问题,特别是疫情全球蔓延及其对世界经济产生不利影响,我国经济下行压力持续加大,但生物医药或将迎难而上。

1、全国本土疫情传播基本阻断
你们从寒冬走来,自暖春走去,白衣执甲,逆行出征,如今终于凯旋归来!
3月17日,41支国家驰援湖北医疗队,共3675人,踏上返程之路,他们驰援湖北期间,总共支援当地14所方舟医院,7所定点医院。风雨中来,花开时走,逆行的战士们终于回家了!
3月24日,湖北省疫情防控指挥部发布通告,从3月25日零时起,在做好健康管理、落实防控措施的前提下,对持有湖北健康码“绿码”的外出务工人员,经核酸检测合格后,采取“点对点、一站式”的办法集中精准输送,确保安全有序返岗。从4月8日零时起,武汉市解除离汉离鄂通道管控措施,有序恢复对外交通,离汉人员凭湖北健康码“绿码”安全有序流动。
湖北地区的逐步解封给各企业复工复产解除了最后一个障碍,湖北的第一批务工者也踏上了南下的列车,中国的抗疫战争已经取得了重大的胜利!
2、疫情全球蔓延
截至北京时间23日12时,除中国外,187个国家和地区累计确诊新冠肺炎病例254499例,累计死亡11307例。世卫组织总干事谭德塞在当天的记者会上说,新冠肺炎大流行呈加速传播趋势,从报告首个病例到第10万个病例用了67天,从10万增长到20万用了11天,从20万到30万病例,仅用了4天。

虽然全国疫情防控形势持续向好、生产生活秩序加快恢复的态势不断巩固和拓展,统筹推进疫情防控和经济社会发展工作取得积极成效。但是我们也面临着不少新情况新问题,特别是境外疫情扩散蔓延及其对世界经济产生不利影响。
全球资本市场亦出现暴跌,美股在短期内,连续多次出现下跌熔断;欧洲股市连续多个交易日狂泻,欧洲债券市场3月18日亦出现了抛售狂潮,多国各期限国债收益率暴涨等,也给我国疫情防控和经济发展带来新的挑战,当前我国经济下行压力持续加大。
多数外贸企业在此次疫情下受挫严重,不少企业面临破产,如何寻找突破口,解决当下危机成为企业关注重点。出口转内销或将成为外贸企业2020年存活的机会。
3、企业抓住机遇,加速发展,转危为机。
疫情之下,整体经济呈现下行趋势,但生物医药行业或将迎难而上。疫情全球范围内爆发,让人们对健康的重视进一步凸显,生物医药产业具有广阔的市场前景。
生物医药作为国家发展新经济的重要环节,在创新发展战略中不可或缺。目前,随着科技的进步,创新医药行业加速发展,中国生物医药行业不断壮大。尤其在近期的疫情影响下,一些生物医药行业,更是将迎来重大发展机遇。
作为新兴的高科技生物制药公司,k1体育官网抓住政府的利好政策,在危机中抓住机遇。在疫情期间做好疫情防控同时,加速推进南昌示范生产线及生产基地建设,如今已经取得阶段性成果,场平工作已经顺利完成。
未来在国家鼓励和社会需求双重驱动下,生物医药行业必将得到进一步快速发展。



